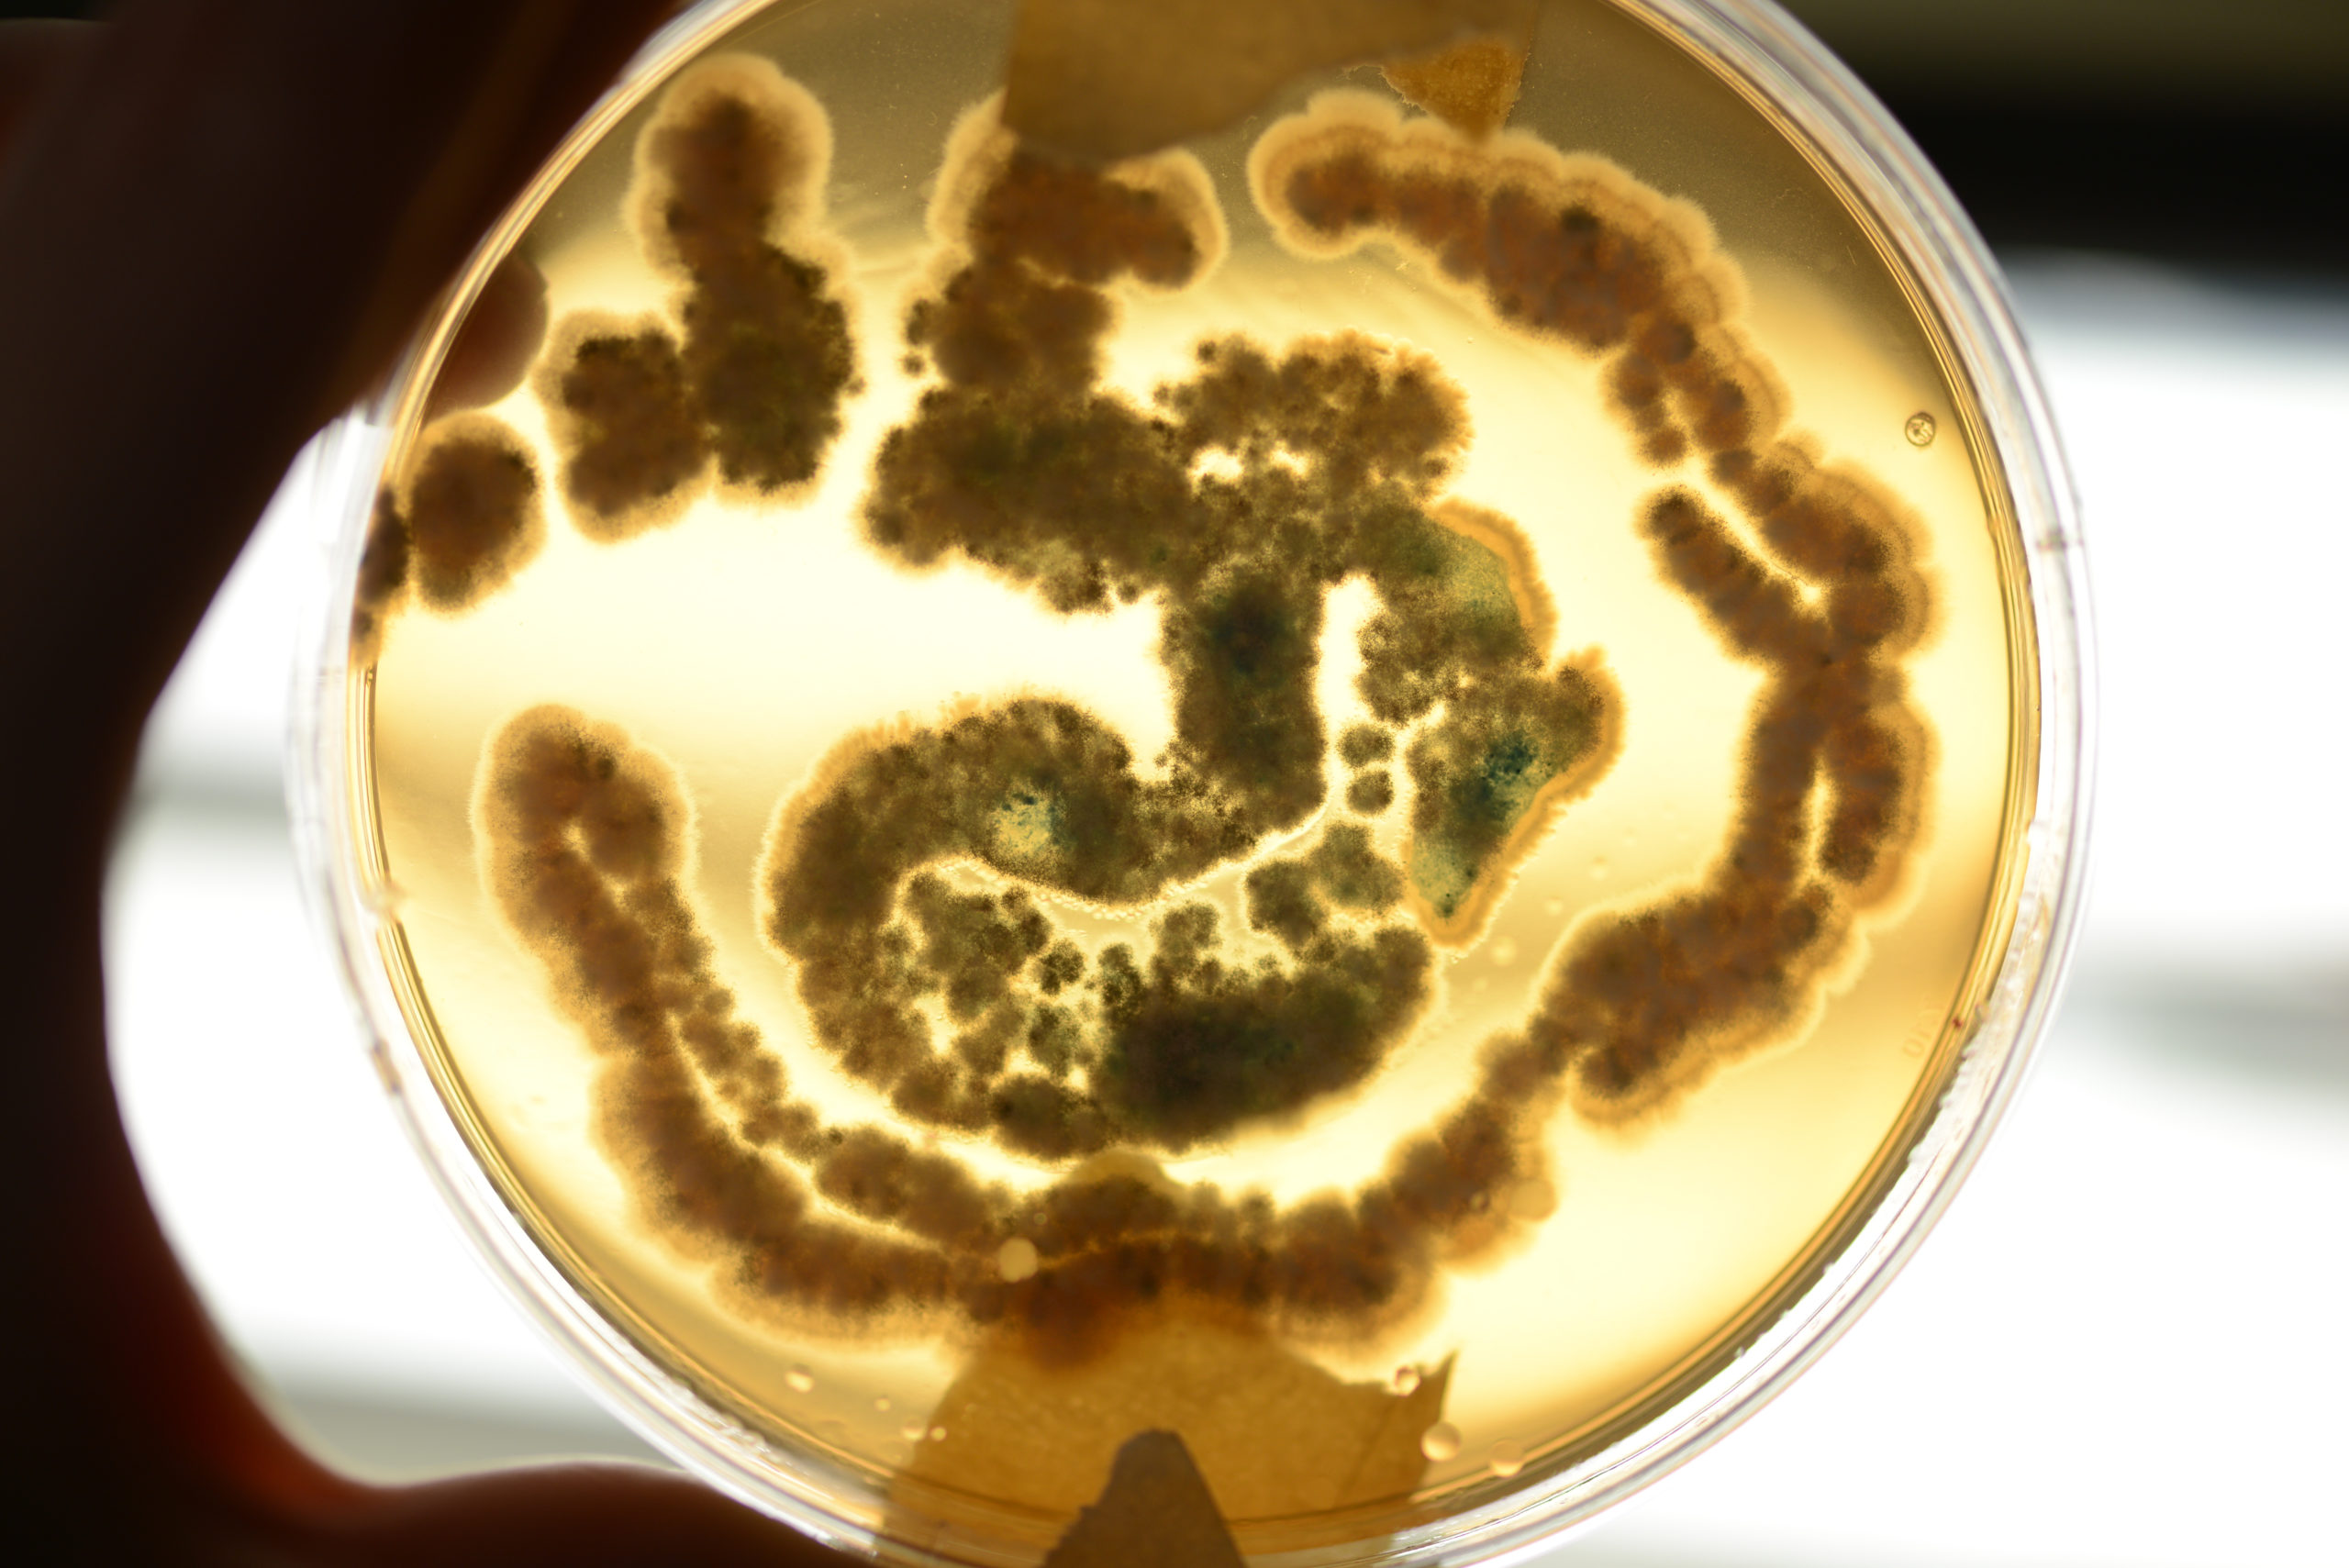
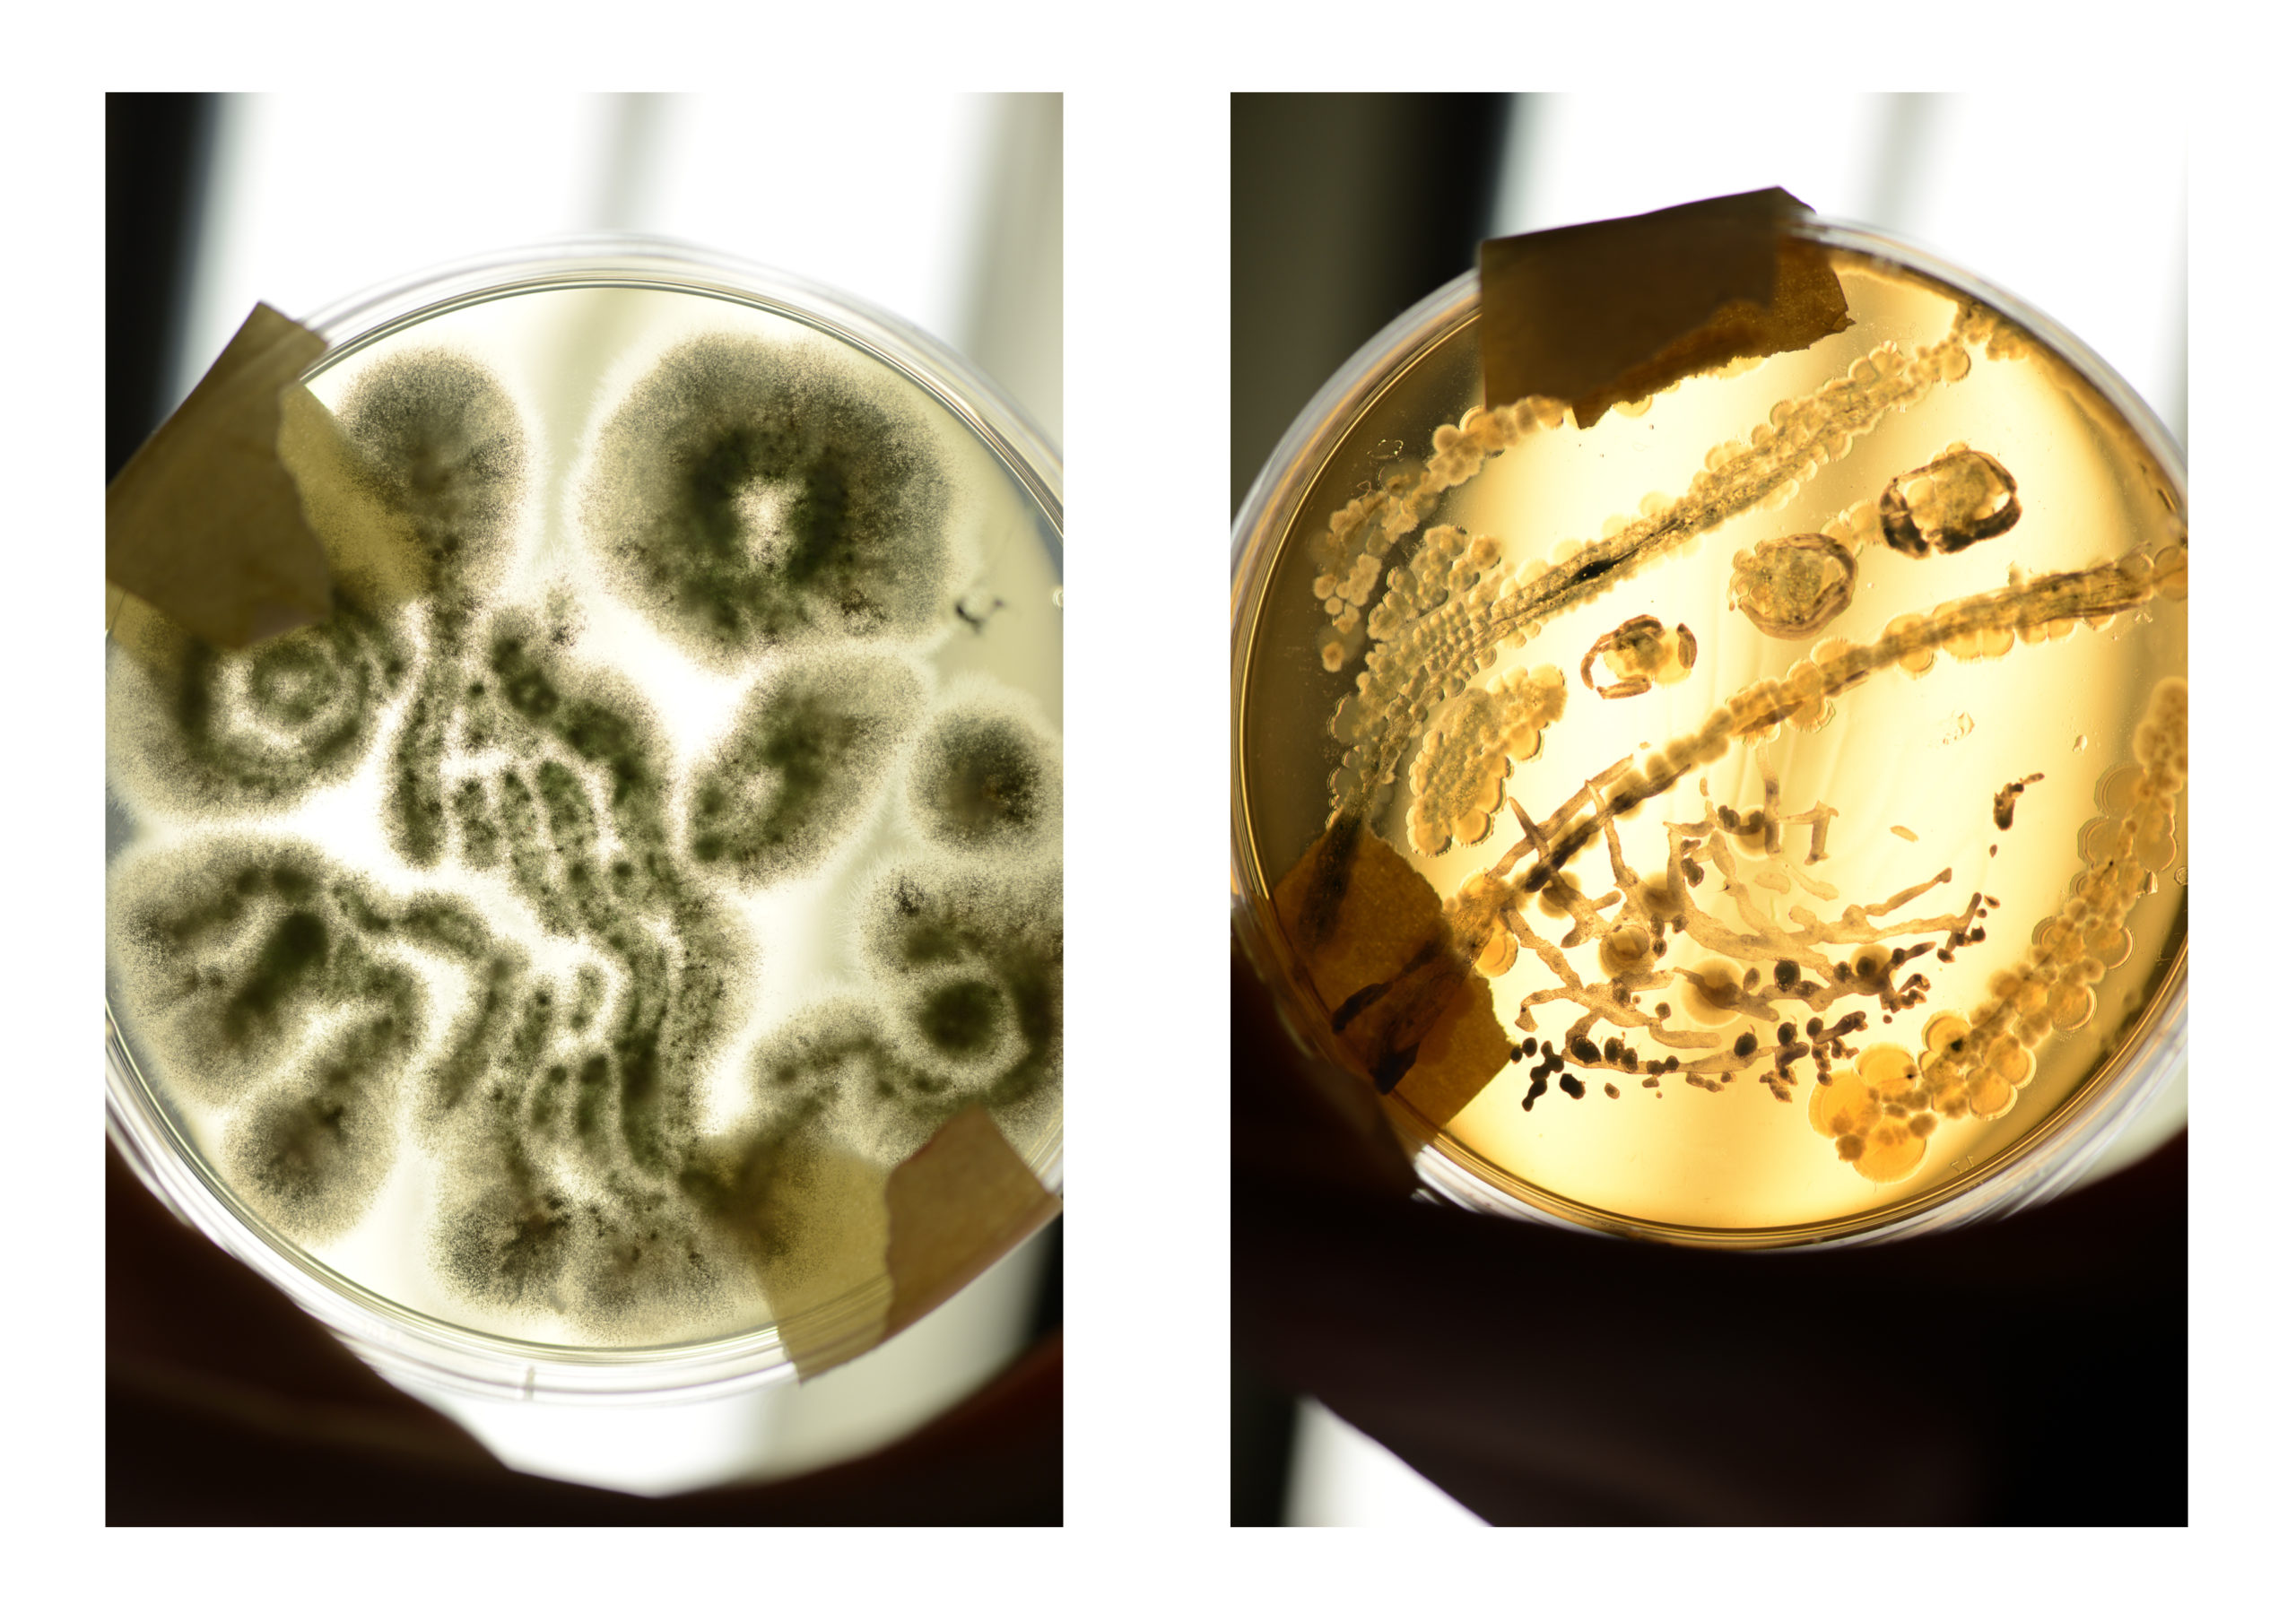

BA (Hons) Fine Art
Catherine McColgan
Introspicere
Catherine McColgan (Born 2002, London) utilises an interdisciplinary practice of Art and Science to tackle larger philosophical questions regarding the potential ethical implications of a contemporary Bio art practice. She uses a microbial perspective to investigate the symbiotic relationships regarding our existence and the human experience. McColgan looks at human cells through scanning electron microscopy (SEM) to present an unrecognisable image of the microbial human form to her audience, showcasing the power of scale regarding abstraction. Researching art, science, and philosophy as a basis for producing work, McColgan probes the human psyche. She explores how we perceive ourselves as a singular organism despite being a varied ecosystem of human and microbial cells working together.
McColgan’s artistic practice is multimedia, consisting of drawings,
paintings, screenprints, petri dishes, clay and bioplastic sculptures. She
uses microbial imagery drawn on paper, creating the SEM series, which is
used as a recurring motif, exploring a range of processes,
experimentation and methodology. The processes she tests may be
scientific, artistic or a hybrid of both (e.g., painting onto Petri dishes to
cultivate samples). She is selective about which artistic processes she
uses to examine her microbial motif, often looking at processes that
mimic those of her subject matter.